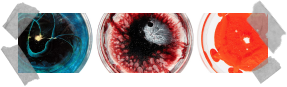

•
#44304
•
11:44:46
•
Weblogs
•
#44304
•
11:44:46
•
Weblogs
Un blog dedicado a esas empresas que compran las grandes corporaciones (Google es experto en esto) para luego cerrarlas al cabo de pocos meses o años 

 •
#42253
•
11:19:12
•
Weblogs
•
#42253
•
11:19:12
•
Weblogs
Un blog dedicado a las escobillas del váter  jojojojojojo Parece ser un blog abandonado de un grupo de amigos que pretenden crear un nuevo modelo de escobilla. Es una idea estupenda, cualquiera que haya usado una escobilla del váter de las actuales sabe que es un invento muy mejorable
jojojojojojo Parece ser un blog abandonado de un grupo de amigos que pretenden crear un nuevo modelo de escobilla. Es una idea estupenda, cualquiera que haya usado una escobilla del váter de las actuales sabe que es un invento muy mejorable 

 •
#42187
•
00:19:16
•
Weblogs
•
#42187
•
00:19:16
•
Weblogs
¿Eres fan de botoncitos y palancas? Este blog se dedica a los paneles de control (este y el anterior, gracias Pan)

 •
#41677
•
10:25:41
•
Weblogs
•
#41677
•
10:25:41
•
Weblogs
Gráficas de lo que es guay y lo que no tanto.

 •
#41235
•
09:51:59
•
Weblogs
•
#41235
•
09:51:59
•
Weblogs
ACUL: Bueno, ya paro con el tema. Dejo por aquí el blog de un señor que tiene muchísima información sobre las casas por catálogo de Sears. Tiene muchísimas fotos de varias casas por todo EEUU en la actualidad.

 •
#41109
•
12:19:04
•
Weblogs
•
#41109
•
12:19:04
•
Weblogs
Cada vez hacen los resúmenes del año más pronto. Aún falta casi todo el mes de diciembre para llegar al 2018 y ya tenemos otro resumen del 2017: ¡El año en Tumblr!

 •
#40445
•
15:02:47
•
Weblogs
•
•
#40445
•
15:02:47
•
Weblogs
• 
La cuenta de Twitter @respuestavideos le da respuesta a las absurdas preguntas planteadas en las descripciones de YouTube 

 •
#39765
•
10:24:11
•
Weblogs
•
#39765
•
10:24:11
•
Weblogs
Cada vez hacen los resúmenes del año más pronto. Aún falta casi todo el mes de diciembre para llegar al 2017 y ya tenemos nuestro primer resumen del 2016: ¡El año en Tumblr!

 •
#39641
•
13:05:26
•
Weblogs
•
#39641
•
13:05:26
•
Weblogs
 •
#38960
•
12:05:40
•
Weblogs
•
#38960
•
12:05:40
•
Weblogs
Si alguna vez necesitas una foto de alguien sujetando un letrero para luego escribirle cualquier tontería en el cartel, que sepas que en este blog hay una gran recopilación de gente quejándose de sus pisos de alquiler con un cartel en la mano 

 •
#38817
•
14:41:22
•
Weblogs
•
#38817
•
14:41:22
•
Weblogs
Ben Affleck con cara de triste. El blog (vamos, un blog dedicado a fotos normales de Ben Affleck, porque no es que le cambie demasiado la cara)

 •
#38691
•
12:33:17
•
Weblogs
•
#38691
•
12:33:17
•
Weblogs
 •
#37448
•
11:33:56
•
Weblogs
•
#37448
•
11:33:56
•
Weblogs
Si tienes una GoPro lo más normal es que te hayas fotografiado mil veces a ti mismo intentando manejarla o mirando si estaba encendida. Este blog recopila caras-gopro 

 •
#36824
•
13:24:39
•
Weblogs
•
#36824
•
13:24:39
•
Weblogs
Echa una lagrimilla nostálgica visitando este galimatías creado con Windows 3.11 y MS-DOS.

 •
#36698
•
12:03:55
•
Weblogs
•
#36698
•
12:03:55
•
Weblogs
ACUL: Si estás interesado en nuevas aventuras gráficas y juegos de rol creados mediante crowdfunding, este es tu blog sobre el tema. Va informando sobre nuevos videojuegos independientes del género que se van publicando o están en proceso.

 •
#36267
•
11:35:29
•
Weblogs
•
#36267
•
11:35:29
•
Weblogs
Me encanta este blog de gráficas y estadísticas. Tiene algunas gráficas muy buenas como esta de los nombres más populares en EEUU durante las últimas décadas. O esta otra de las palabras más habituales en las canciones del billboard. O, para acabar, esta otra del auge de los nombres acabados en N.

 •
#36137
•
15:57:35
•
Weblogs
•
•
#36137
•
15:57:35
•
Weblogs
• 
Me acabo de enterar de que PostSecret, el blog donde la gente manda sus secretos (y que lleva muchos años en activo) tiene un contestador automático para mandar secretos por teléfono.

 •
#35517
•
12:46:55
•
Weblogs
•
#35517
•
12:46:55
•
Weblogs
El blog de la gente que deja espacio en el metro para que se acomoden los gatos  (esto se nos está yendo de las manos)
(esto se nos está yendo de las manos)

 •
#35516
•
12:43:50
•
Weblogs
•
#35516
•
12:43:50
•
Weblogs
No me llamo nena. El blog de las chicas que se quejan de los piropos (¡nenaaaaaa! ¡que con menos culo también se cagaaaaaa!)

 •
#35446
•
09:10:46
•
Weblogs
•
#35446
•
09:10:46
•
Weblogs
ACUL: Todo es mejor cuando le metes un poquito de Batman (na-na-na-na-na-na-na-na-na)

 •
#35398
•
09:32:38
•
Weblogs
•
#35398
•
09:32:38
•
Weblogs
 •
#35382
•
12:25:58
•
Weblogs
•
#35382
•
12:25:58
•
Weblogs
Gente con aspecto guay llevando unas Google Glass. El blog.

 •
#34809
•
11:46:30
•
Weblogs
•
#34809
•
11:46:30
•
Weblogs
Weblog donde hacen estudios sobre la tipografía en la ciencia ficción.

 •
#33648
•
14:11:29
•
Weblogs
•
#33648
•
14:11:29
•
Weblogs
Si eres un enganchado a las redes sociales (no olvides seguirnos en twitter y facebook), aquí os dejo una infografía que nos indican como debería ser el post perfecto en nuestras redes sociales.

 •
#33494
•
10:21:27
•
Weblogs
•
#33494
•
10:21:27
•
Weblogs
 •
#33415
•
07:53:15
•
Weblogs
•
#33415
•
07:53:15
•
Weblogs
 •
#33313
•
07:27:53
•
Weblogs
•
#33313
•
07:27:53
•
Weblogs
El mundo del cartón, todo lo que siempre saber sobre el cartón, los artículos mas interesantes sobre cartón, los productos hechos de cartón más cartonianos del mundo del cartón, todo ello y mucho más en Carton Banks 

 •
#33277
•
12:31:33
•
Weblogs
•
#33277
•
12:31:33
•
Weblogs
 •
#32644
•
08:25:11
•
Weblogs
•
#32644
•
08:25:11
•
Weblogs
¡Uooooh! Me encanta este blog: I'm Google. Puedes ver cómo las fotos son similares unas a otras y van cambiando poco a poco... 

 •
#32601
•
08:23:01
•
Weblogs
•
#32601
•
08:23:01
•
Weblogs
ACUL: ¿No sabes cómo conjuntar la ropa? Este blog también te ayuda.
 •
#32600
•
08:22:12
•
Weblogs
•
#32600
•
08:22:12
•
Weblogs
¿No sabes cómo conjuntar la ropa? Este blog te ayuda.
 •
#32501
•
08:26:29
•
Weblogs
•
#32501
•
08:26:29
•
Weblogs
Blog dedicado al minúsculo arte de pintar uñas.
 •
#32499
•
08:16:30
•
Weblogs
•
#32499
•
08:16:30
•
Weblogs
Un extraño plato al día da alegría durante 2013 [relacionado]
 •
#32262
•
11:29:16
•
Weblogs
•
#32262
•
11:29:16
•
Weblogs
Giphy, sitio web donde encontrar gifs clasificados, algunos los pondremos en Oink TV!
 •
#32246
•
08:17:28
•
Weblogs
•
#32246
•
08:17:28
•
Weblogs
Grandísimo el blog de Cinismo Ilustrado. Me extraña que no haya estado aquí antes en Oink! 

 •
#32149
•
20:19:18
•
Weblogs
•
#32149
•
20:19:18
•
Weblogs
Hace unos días Facebook sacó un buscador "Facebook graph search", pues ya hay blogs que se dedican a recopilar búsquedas de lo más variopintas.

 •
#31851
•
07:58:02
•
Weblogs
•
#31851
•
07:58:02
•
Weblogs
Saque de honor. El blog (gracias anonimo)
 •
#31807
•
07:45:24
•
Weblogs
•
#31807
•
07:45:24
•
Weblogs
¡Oh, sí! ¡Ha vuelto! ¡Es él! ¡El único! ¡El genuino! ¡El inimitable! ¡InternezZ! 

 •
#31618
•
08:20:42
•
Weblogs
•
#31618
•
08:20:42
•
Weblogs
 •
#31605
•
16:37:22
•
Weblogs
•
#31605
•
16:37:22
•
Weblogs
 •
#31519
•
08:31:07
•
Weblogs
•
#31519
•
08:31:07
•
Weblogs
 •
#31517
•
08:28:15
•
Weblogs
•
#31517
•
08:28:15
•
Weblogs
 •
#31268
•
12:35:55
•
Weblogs
•
#31268
•
12:35:55
•
Weblogs
 •
#30650
•
08:11:13
•
Weblogs
•
#30650
•
08:11:13
•
Weblogs
El mismo robot una y otra vez.
 •
#30334
•
08:07:51
•
Weblogs
•
#30334
•
08:07:51
•
Weblogs
 •
#30250
•
10:00:07
•
Weblogs
•
#30250
•
10:00:07
•
Weblogs
 •
#30172
•
08:14:35
•
Weblogs
•
#30172
•
08:14:35
•
Weblogs
Un extraño plato al día da alegría.
 •
#29955
•
07:59:20
•
Weblogs
•
#29955
•
07:59:20
•
Weblogs
 •
#29294
•
16:05:42
•
Weblogs
•
#29294
•
16:05:42
•
Weblogs
 •
#29045
•
08:15:16
•
Weblogs
•
#29045
•
08:15:16
•
Weblogs
No tengo ni idea de qué va esta página (de moda, supongo) pero ir bajando y ver cómo van cambiando los productos de color me ha molado mucho 
(519 links encontrados - 11 páginas - 50 links por página)




 jojojojojojo Parece ser un blog abandonado de un grupo de amigos que pretenden crear un nuevo modelo de escobilla. Es una idea estupenda, cualquiera que haya usado una escobilla del váter de las actuales sabe que es un invento muy mejorable
jojojojojojo Parece ser un blog abandonado de un grupo de amigos que pretenden crear un nuevo modelo de escobilla. Es una idea estupenda, cualquiera que haya usado una escobilla del váter de las actuales sabe que es un invento muy mejorable 


















 (esto se nos está yendo de las manos)
(esto se nos está yendo de las manos)